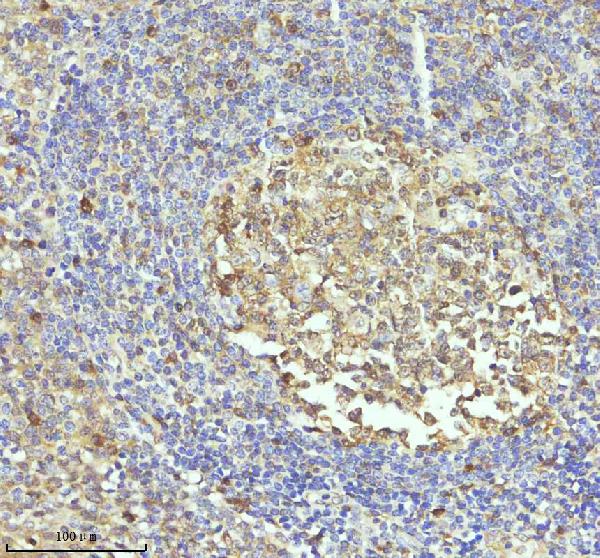
IHC - Anti-Caspase 3 Rabbit Monoclonal Antibody ABO16560

Anti-Caspase 3 Rabbit Monoclonal Antibody
- SPECIFICATION
- CITATIONS
- PROTOCOLS
- BACKGROUND

Application
| WB, IHC, IP |
|---|---|
| Primary Accession | P42574 |
| Host | Rabbit |
| Isotype | IgG |
| Reactivity | Rat, Human, Mouse |
| Clonality | Monoclonal |
| Format | Liquid |
| Description | Anti-Caspase 3 Rabbit Monoclonal Antibody . Tested in WB, IHC, IP applications. This antibody reacts with Human, Mouse, Rat. |
| Gene ID | 836 |
|---|---|
| Other Names | Caspase-3, CASP-3, 3.4.22.56, Apopain, Cysteine protease CPP32, CPP-32, Protein Yama, SREBP cleavage activity 1, SCA-1, Caspase-3 subunit p17, Caspase-3 subunit p12, CASP3, CPP32 {ECO:0000303|PubMed:7983002} |
| Calculated MW | 35 kDa |
| Application Details | WB 1:500-1:2000 IHC 1:50-1:200 IP 1:50 |
| Contents | Rabbit IgG in phosphate buffered saline, pH 7.4, 150mM NaCl, 0.02% sodium azide and 50% glycerol, 0.4-0.5mg/ml BSA. |
| Clone Names | Clone: 30C96 |
| Immunogen | A synthesized peptide derived from human Caspase 3 |
| Purification | Affinity-chromatography |
| Storage | Store at -20°C for one year. For short term storage and frequent use, store at 4°C for up to one month. Avoid repeated freeze-thaw cycles. |
| Name | CASP3 |
|---|---|
| Synonyms | CPP32 {ECO:0000303|PubMed:7983002} |
| Function | Thiol protease that acts as a major effector caspase involved in the execution phase of apoptosis (PubMed:18723680, PubMed:20566630, PubMed:23650375, PubMed:35338844, PubMed:35446120, PubMed:7596430). Following cleavage and activation by initiator caspases (CASP8, CASP9 and/or CASP10), mediates execution of apoptosis by catalyzing cleavage of many proteins (PubMed:18723680, PubMed:20566630, PubMed:23650375, PubMed:7596430). At the onset of apoptosis, it proteolytically cleaves poly(ADP-ribose) polymerase PARP1 at a '216-Asp-|-Gly-217' bond (PubMed:10497198, PubMed:16374543, PubMed:7596430, PubMed:7774019). Cleaves and activates sterol regulatory element binding proteins (SREBPs) between the basic helix-loop-helix leucine zipper domain and the membrane attachment domain (By similarity). Cleaves and activates caspase-6, -7 and -9 (CASP6, CASP7 and CASP9, respectively) (PubMed:7596430). Cleaves and inactivates interleukin-18 (IL18) (PubMed:37993714, PubMed:9334240). Involved in the cleavage of huntingtin (PubMed:8696339). Triggers cell adhesion in sympathetic neurons through RET cleavage (PubMed:21357690). Cleaves DSG2 in response to apoptosis resulting in a loss of full length DSG2 at desmosome cell junctions and subsequent loss of cell-cell adhesion (PubMed:17559062). Also cleaves JUP in response to apoptosis (PubMed:17559062). Cleaves and inhibits serine/threonine-protein kinase AKT1 in response to oxidative stress (PubMed:23152800). Acts as an inhibitor of type I interferon production during virus-induced apoptosis by mediating cleavage of antiviral proteins CGAS, IRF3 and MAVS, thereby preventing cytokine overproduction (PubMed:30878284). Also involved in pyroptosis by mediating cleavage and activation of gasdermin-E (GSDME) (PubMed:35338844, PubMed:35446120). Cleaves XRCC4 and phospholipid scramblase proteins XKR4, XKR8 and XKR9, leading to promote phosphatidylserine exposure on apoptotic cell surface (PubMed:23845944, PubMed:33725486). Cleaves BIRC6 following inhibition of BIRC6-caspase binding by DIABLO/SMAC (PubMed:36758104, PubMed:36758106). |
| Cellular Location | Cytoplasm. |
| Tissue Location | Highly expressed in lung, spleen, heart, liver and kidney. Moderate levels in brain and skeletal muscle, and low in testis. Also found in many cell lines, highest expression in cells of the immune system. |

Thousands of laboratories across the world have published research that depended on the performance of antibodies from Abcepta to advance their research. Check out links to articles that cite our products in major peer-reviewed journals, organized by research category.
info@abcepta.com, and receive a free "I Love Antibodies" mug.
Provided below are standard protocols that you may find useful for product applications.
If you have used an Abcepta product and would like to share how it has performed, please click on the "Submit Review" button and provide the requested information. Our staff will examine and post your review and contact you if needed.
If you have any additional inquiries please email technical services at tech@abcepta.com.













 Foundational characteristics of cancer include proliferation, angiogenesis, migration, evasion of apoptosis, and cellular immortality. Find key markers for these cellular processes and antibodies to detect them.
Foundational characteristics of cancer include proliferation, angiogenesis, migration, evasion of apoptosis, and cellular immortality. Find key markers for these cellular processes and antibodies to detect them. The SUMOplot™ Analysis Program predicts and scores sumoylation sites in your protein. SUMOylation is a post-translational modification involved in various cellular processes, such as nuclear-cytosolic transport, transcriptional regulation, apoptosis, protein stability, response to stress, and progression through the cell cycle.
The SUMOplot™ Analysis Program predicts and scores sumoylation sites in your protein. SUMOylation is a post-translational modification involved in various cellular processes, such as nuclear-cytosolic transport, transcriptional regulation, apoptosis, protein stability, response to stress, and progression through the cell cycle. The Autophagy Receptor Motif Plotter predicts and scores autophagy receptor binding sites in your protein. Identifying proteins connected to this pathway is critical to understanding the role of autophagy in physiological as well as pathological processes such as development, differentiation, neurodegenerative diseases, stress, infection, and cancer.
The Autophagy Receptor Motif Plotter predicts and scores autophagy receptor binding sites in your protein. Identifying proteins connected to this pathway is critical to understanding the role of autophagy in physiological as well as pathological processes such as development, differentiation, neurodegenerative diseases, stress, infection, and cancer.